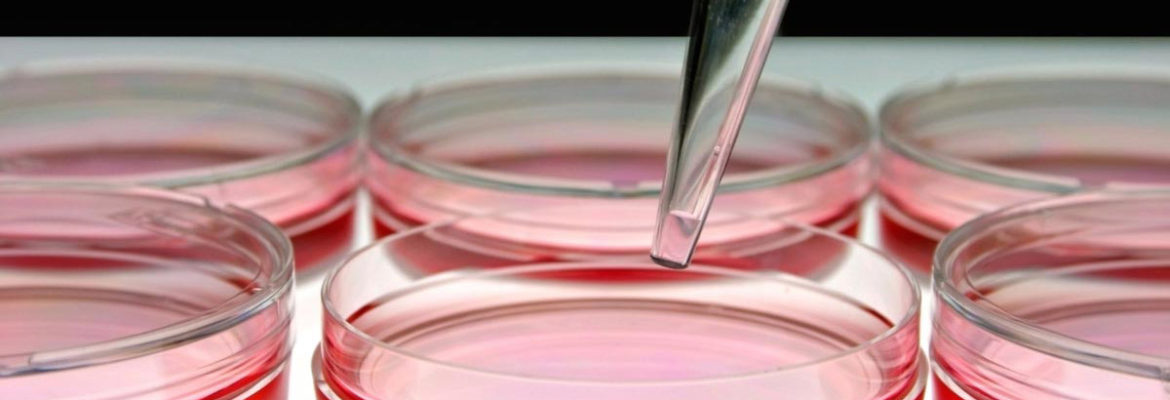

Researchers study fungi to turn food waste into sustainable bioplastic
![]() |
(Natural News) In a world in which 9 million people die from hunger each year, it’s absolutely unacceptable that 40 percent of all foods are wasted. The food industry is responsible for creating high amounts of biodegradable waste, and finding ways to put this waste to good use could have a significant positive impact on… |
Read Original Article: Researchers study fungi to turn food waste into sustainable bioplastic »
Powered by WPeMatico